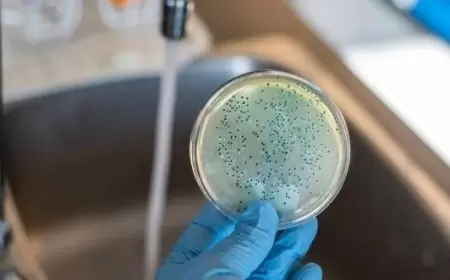
Vəba sürətlə yayılır - Yüzlərlə ölü, minlərlə yoluxan var

Bu sayt sizə daha yaxşı xidmət göstərə bilmək üçün kukilərdən istifadə edir.
Hamısı
Allergologiya
Vitaminlər
Andrologiya
Artrologiya
Cərrahiyyə
Dermatovenerologiya
Endokrinologiya
Fizioterapiya
Ftiziatriya
Ginekologiya
Hematologiya
Hepatologiya
İnfektologiya
Kardiologiya
Qastroenterologiya
Nefrologiya
Nevrologiya
Oftalmologiya
Onkologiya
Ortopediya
Otorinolarinqologiya
Parazitologiya
Pediatriya
Pulmonologiya
Revmatologiya
Terapiya
Travmatologiya
Urologiya
OTC məhsullar
- Ana səhifə
- Platforma
-
Dərmanlar
- Hamısı
- Allergologiya
- Vitaminlər
- Andrologiya
- Artrologiya
- Cərrahiyyə
- Dermatovenerologiya
- Endokrinologiya
- Fizioterapiya
- Ftiziatriya
- Ginekologiya
- Hematologiya
- Hepatologiya
- İnfektologiya
- Kardiologiya
- Qastroenterologiya
- Nefrologiya
- Nevrologiya
- Oftalmologiya
- Onkologiya
- Ortopediya
- Otorinolarinqologiya
- Parazitologiya
- Pediatriya
- Pulmonologiya
- Revmatologiya
- Terapiya
- Travmatologiya
- Urologiya
- OTC məhsullar
- Xəbərlər
- Əlaqə
- Yazılar
- Sorğular
- Klinikalar
- Həkimlər